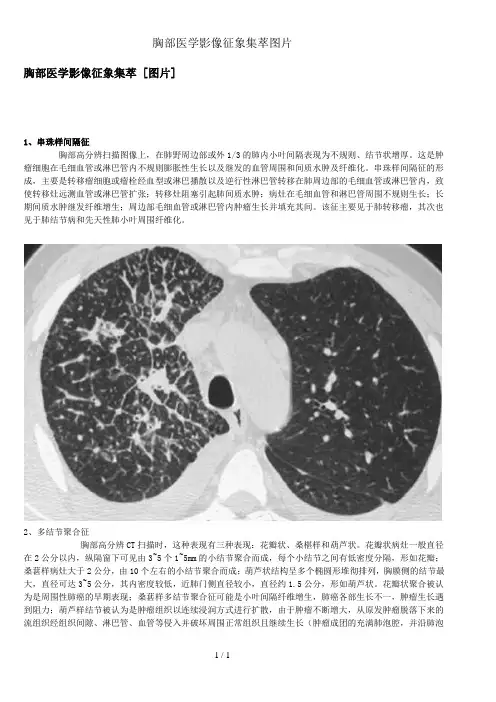
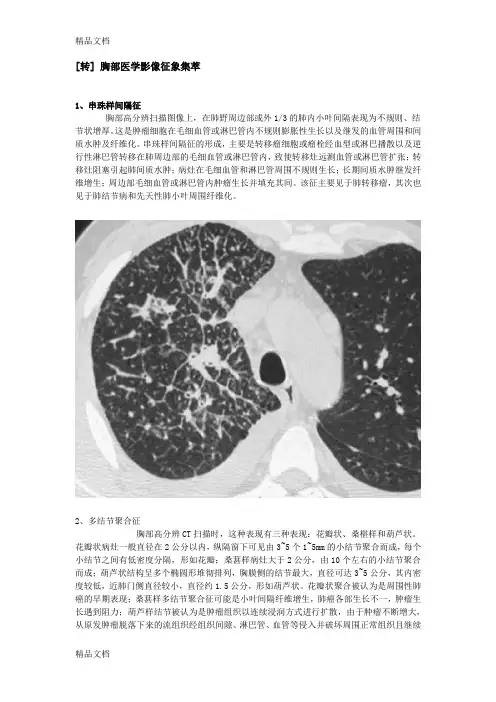

临床胸部影像(珍藏版)
- 格式:ppt
- 大小:29.29 MB
- 文档页数:236

胸部医学影像征象集萃 [图片]1、串珠样间隔征胸部高分辨扫描图像上,在肺野周边部或外1/3的肺内小叶间隔表现为不规则、结节状增厚。
这是肿瘤细胞在毛细血管或淋巴管内不规则膨胀性生长以及继发的血管周围和间质水肿及纤维化。
串珠样间隔征的形成,主要是转移瘤细胞或瘤栓经血型或淋巴播散以及逆行性淋巴管转移在肺周边部的毛细血管或淋巴管内,致使转移灶远测血管或淋巴管扩张;转移灶阻塞引起肺间质水肿;病灶在毛细血管和淋巴管周围不规则生长;长期间质水肿继发纤维增生;周边部毛细血管或淋巴管内肿瘤生长并填充其间。
该征主要见于肺转移瘤,其次也见于肺结节病和先天性肺小叶周围纤维化。
2、多结节聚合征胸部高分辨CT扫描时,这种表现有三种表现:花瓣状、桑椹样和葫芦状。
花瓣状病灶一般直径在2公分以内,纵隔窗下可见由3~5个1~5mm的小结节聚合而成,每个小结节之间有低密度分隔,形如花瓣;桑葚样病灶大于2公分,由10个左右的小结节聚合而成;葫芦状结构呈多个椭圆形堆彻排列,胸膜侧的结节最大,直径可达3~5公分,其内密度较低,近肺门侧直径较小,直径约1.5公分,形如葫芦状。
花瓣状聚合被认为是周围性肺癌的早期表现;桑葚样多结节聚合征可能是小叶间隔纤维增生,肺癌各部生长不一,肿瘤生长遇到阻力;葫芦样结节被认为是肿瘤组织以连续浸润方式进行扩散,由于肿瘤不断增大,从原发肿瘤脱落下来的流组织经组织间隙、淋巴管、血管等侵入并破坏周围正常组织且继续生长(肿瘤成团的充满肺泡腔,并沿肺泡空向周围继续生长,膨胀性扩大)或肿瘤沿肺泡壁伏壁生长,都可以形成此征。
3、反晕征和晕征的表现相反,在高分辨胸部CT肺窗上观察,病灶中心密度低呈磨玻璃状,周围是新月形或环形高密度,厚度至少2mm。
这种表现是由于中心为低密度由肺泡间隔浸润和细胞碎片,周围环形或新月形高密度是肺泡管机化性肺炎或致密、均匀肺泡间细胞浸润所导致的致密气腔实变。
起初认为对诊断隐原性肺泡炎有特异性,但随后发现该征象也见于类球孢子菌病的描述中。



影像解剖珍藏版胸部X线片系统读片原理24个字母(A-X)系统读片法,可以减少漏诊。
胸部X线片系统读片原理A(Airway)气道在胸上部,看它是否居中,脊柱是否直线经过,气管有无移位,有无纤维组织牵拉使肺容积缩牵、过度充气及压迫。
有无支气管气管巨大症,肺叶开口压迫、狭窄、隆突受压等支气管肺癌征象。
B(Bone)肋骨距是否某侧缩窄,肋骨有无缺损,如第一肋骨上缘缺损,有硬皮病、类风湿性关节炎的可能。
第7~9肋骨下缘缺损示主动脉狭窄,见于儿童先天心脏病;法乐氏四联症可见左肋下缘缺损。
咳嗽所致骨折,可见于6~9肋,第7肋腋后线可见叉形肋。
鸽胸与先天性房室间隔缺损相关,也见于儿童哮喘症或脊柱侧凸严重时伴通气功能降低者。
骨脱钙可见于类固醇治疗患者、老年、肾病、或其他代病者。
C(Cor)心脏右缘有两弓,左缘有四弓。
右两弓消失见于漏斗胸、右中叶萎缩、肺炎。
形状变化或心脏扩大,见于先天性心脏病、心力衰竭。
D(Diaphragm)膈肌右高于左半个肋间隙,一侧高,考虑胸部肿瘤、纤维组织牵拉、膈下脓肿。
半侧膈肌升高考虑外伤、中风、颈部感染或肿瘤、肺炎或放射治疗后。
右侧可见膈肌伴弯刀征。
医学.教育网原。
创E(Esophagus)食管位于气管右,若有空气液面,考虑食管不能松驰或狭窄。
F(Fissures)肺裂将各肺分为各叶,左右各有一斜裂,右侧有横裂,斜裂下端止于膈肌,决不止于前胸壁,有异常时示有病变。
G(Gastric bubble)胃泡在左侧,若在右,考虑脏转位,胃泡不见,考虑食管不能松驰。
胃泡在心右可能为膈疝。
H(Hila)肺门移位示肺部分萎缩、过度充气等,肺门区扩大可能是肺癌转移、肺感染、免疫疾病或结节病。
I(Interstitium)间质性浸润分两型,间质型看上部心前区,下部可因妇妇女乳房影加重。
肺泡型浸润,因肺泡灌注水、脓、血或蛋白质样物质,见于Goodpasture氏征、肺含铁血黄素沉着症、鳞状上皮脱落间质性肺炎等。
[转] 胸部医学影像征象集萃1、串珠样间隔征胸部高分辨扫描图像上,在肺野周边部或外1/3的肺内小叶间隔表现为不规则、结节状增厚。
这是肿瘤细胞在毛细血管或淋巴管内不规则膨胀性生长以及继发的血管周围和间质水肿及纤维化。
串珠样间隔征的形成,主要是转移瘤细胞或瘤栓经血型或淋巴播散以及逆行性淋巴管转移在肺周边部的毛细血管或淋巴管内,致使转移灶远测血管或淋巴管扩张;转移灶阻塞引起肺间质水肿;病灶在毛细血管和淋巴管周围不规则生长;长期间质水肿继发纤维增生;周边部毛细血管或淋巴管内肿瘤生长并填充其间。
该征主要见于肺转移瘤,其次也见于肺结节病和先天性肺小叶周围纤维化。
2、多结节聚合征胸部高分辨CT扫描时,这种表现有三种表现:花瓣状、桑椹样和葫芦状。
花瓣状病灶一般直径在2公分以内,纵隔窗下可见由3~5个1~5mm的小结节聚合而成,每个小结节之间有低密度分隔,形如花瓣;桑葚样病灶大于2公分,由10个左右的小结节聚合而成;葫芦状结构呈多个椭圆形堆彻排列,胸膜侧的结节最大,直径可达3~5公分,其内密度较低,近肺门侧直径较小,直径约1.5公分,形如葫芦状。
花瓣状聚合被认为是周围性肺癌的早期表现;桑葚样多结节聚合征可能是小叶间隔纤维增生,肺癌各部生长不一,肿瘤生长遇到阻力;葫芦样结节被认为是肿瘤组织以连续浸润方式进行扩散,由于肿瘤不断增大,从原发肿瘤脱落下来的流组织经组织间隙、淋巴管、血管等侵入并破坏周围正常组织且继续生长(肿瘤成团的充满肺泡腔,并沿肺泡空向周围继续生长,膨胀性扩大)或肿瘤沿肺泡壁伏壁生长,都可以形成此征。
3、反晕征和晕征的表现相反,在高分辨胸部CT肺窗上观察,病灶中心密度低呈磨玻璃状,周围是新月形或环形高密度,厚度至少2mm。
这种表现是由于中心为低密度由肺泡间隔浸润和细胞碎片,周围环形或新月形高密度是肺泡管机化性肺炎或致密、均匀肺泡间细胞浸润所导致的致密气腔实变。
起初认为对诊断隐原性肺泡炎有特异性,但随后发现该征象也见于类球孢子菌病的描述中。